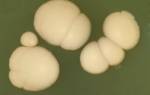

Так как во время беременности пользоваться «стандартными» средствами от растяжек не рекомендуется, лучше использовать те, которые безопасны, не только для молодой мамы, но и для малыша.
Немецкий крем от растяжек «Sanosan mama» предназначен специально для беременных. По утверждению производителей, он помогает предупреждать появление растяжек и восстанавливает тонус кожи. И, кроме того, безвреден для младенцев.
- Состав крема Sanosan
- Использование крема
- Отзывы
Крем разработан на основе тщательно подобранных натуральных ингредиентов. Они безопасны как для беременных, так и молодых кормящих мам и их детей. Кроме тог, компоненты крема оказывают питательное действие на кожу и повышают её эластичность.
В состав крема входят натуральные питательные компоненты, масло жожоба, хитозан и вытяжка из семян гибискуса. «Sanosan mama» как и большинство современных средств не содержит парафинового масла и красителей.
Саносан производиться в Германии компаний Манн и Шрёдер с использованием натурального ланолина согласно рекомендациям Немецкого Федерального института оценки риска и Национальной комиссией по грудному вскармливанию. Естественно, средство клинически протестировано.
Рассмотрим действие трех основных составляющих «Sanosan mama».
Масло Жожоба.
Масло Жожоба добывают отжимом из семян одноименного кустарника. Масло обладает редкими лечебными и косметическими свойствами. По химическому составу оно идентично спермацету, который присутствует в составе дорогостоящих омолаживающих кремов.
Масло Жожоба является идеальным увлажнителем и смягчает верхний слой кожи, делая её более мягкой и эластичной. Масло питает кожу витаминами и минералами, и ускоряет процесс обновления клеток. Часто оно используют в борьбе с морщинами.
Еще одним достоинством масла является его гипоаллергенность. Что позволяет использовать для чувствительной и детской кожей.
Вытяжка из семян Гибискуса (Гибискин).
Вытяжка является уникальным источником протеинов, кальция и витаминов. Она обеспечивает активное питание и увлажнение кожи при повышенных нагрузках. Экстракт востребован в различных SPA-процедурах и в косметике для юношеской кожи.
Хитозан.
Хитозан является производным продуктом хитина. Он содержится в панцирях морских крабов, креветок, криля, омаров и раков. В медицине его используют для заживления без образования рубцов.
Хитозан используют как увлажнитель, пленкообразующие и противовоспалительное средства. Он образует влагоудерживающеую пленку, позволяющее коже дышать и одновременно держащую влагу. Часто вещество встречается в составе кремов, шампуней, гелей для душа, мыла и других средств.
Полный состав крема «Sanosan mama»: вода, Гибискус, глицерин, изопропил пальмитат, полиглицерил-3-полирицинолеат, пчелиный воск, масло Жожоба, сорбитан олеат, сульфат магния, токоферола ацетат, хитозан лактат, отдушка, микрокристаллический воск, феноксиэтанол, бензиловый спирт, бензилсалицилат, гераниол, бутилфенил метилпропиональ, гидроксиизогексил 3-циклогексен карбоксальдегид, цитронеллол, сорбат калия, лимонная кислота, гексил цинамал, альфа-изометил ионон.
Крем нужно нанести на кожу в тех местах, где обычно появляются растяжки. Это грудь, живот и ноги. Его равномерно наносят на места появления стрий и втирают в кожу осторожными круговыми движениями.
Использование Саносана возможно с первого месяца беременности. Обычно крем применяют 1-2 раза в течения дня. Крем можно использовать вместе с легким массажем проблемных зон, где ожидается появление растяжек.
Ролик, посвященный массажу беременных:
А вот два отзыва, посвященные Саносану, которые мы взяли с сайта Отзовик.
Я использовала этот крем во время второй беременности. В перую беременность пользовалась кремом «Наша мама» и могу сказать, что он мне понравился гораздо меньше.
Крем Sanosan — густой и жирный, нужно дать время, чтобы он впитался. Но если я обычно не люблю все эти жирные кремы, то тут у меня наоборот сработал принцип, чем жирнее, тем больше кожа защищена (это уже психологически я себя так видимо настроила). Запах у крема приятный. Что касается растяжек, то у меня они все равно появились.
Пользовалась 2 раза в день.
http://otzovik.com/review_142427.html
Какой-то специальной инструкции по использованию к крему не прилагается, а потому всю информацию о креме мы читаем на упаковке.
Я не советовала бы именно этот крем женщинам на раннем сроке по другой причине. Дело в том, что в первом триместре у многих случается такая неприятность, как токсикоз, когда тошнить начинает от вида собственного отражения в зеркале, не говоря уж о каких-то продуктах питания или запахов. А крем Sanosan от растяжек как раз запах имеет.
Не скажу, что аромат крема от растяжек в период беременности Сфносан какой-то резкий или неприятный. Сейчас он мне даже очень нравится, но на период токсикоза я бы просто советовала выбирать средства совсем не имеющие запаха, чтоб не усугублять и без того не легкое состояние.
Кстати, использовать именно этот крем можно на всех требующих ухода частях тела. Он подходит и для живота, и для груди (кроме области сосков, почему — не знаю, так написано на упаковке), для бедер.
Но по телу он распределяется легко, особенно, если перед тем, как начать распределять его по телу выдавить его и дать минутку-другую полежать на теле и согреться. Впитывается крем не сразу, после распределения по кожи с элементами массажа лучше еще несколько минут ничего не одевать на себя сверху, так и крем лучше впитается и тело подышит.
http://otzovik.com/review_478375.html
Растяжки нередко становятся причиной депрессии, стресса, развития комплексов. Растяжки не сказываются на здоровье женщины, но в большей степени влияют на эстетическую красоту тела, портя ее.
С появлением растяжек (иными словами – стрий) многие девушки отказываются от ношения платьев, купальников, коротких юбок и шортов.
Причин появления растяжек много, начиная от диеты и заканчивая рождением ребенка.
В связи с тем, что косметология шагнула далеко вперед, некоторые производители предлагают специальные крема. Благодаря им девушки могут маскировать растяжки, а порой и вовсе избавляться от них – делать практически незаметным, ускорить процессы рассасывания.
Но выбор постоянно растет, ассортимент продуктов расширяется, и подобрать идеальный становится не так и просто. В связи с этим мы подготовили рейтинг, включающий в себя 7 лучших кремов против растяжек.
Благодаря им вы не только приведете тело в форму, но и повысите собственную самооценку.
В наш рейтинг лучших кремов от растяжек, используемых беременными женщинами, вошли следующие марки и их продукты:
- Sanosan Mama;
- Mama Comfort Против растяжек;
- 9 месяцев Крем для профилактики и коррекции растяжек;
- Weleda Schwangerschafts-Pflegeöl;
- Mustela Stretch Marks Prevention;
- Maternea Anti-Stretch Marks Body Cream;
- Avent Indulgent Body Cream.
Ниже мы расскажем подробнее о каждом из перечисленных продуктов, отметим их достоинства и недостатки. Надеемся, статья будет полезна вам в дальнейшем поиске идеального средства. Приятного прочтения и удачных покупок!
Один из бюджетных вариантов качественного товара зарубежного производителя (Германия).
В сравнении со многими другими марками, в состав крема входят исключительно натуральные компоненты – глицерин и цинк, масло жожоба, лимонная кислота и пчелиный воск.
Крем не только предотвращает появлений стрий, но и уменьшает их количество и видимость на разных участках тела. Снимает зуд и раздражение, питает кожу, выравнивая ее. Тюбика в среднем хватает на 2-3 недели.
| Страна | Германия |
| Состав | 50 |
| Объем, в мл | глицерин, гибискус, масло жожоба |
Цена: от 375 до 410 рублей.
Уникальный крем посоветовала тетя, она тоже страдала от растяжек после родов. Крем имеет неприятный запах, но его действие меня удивляет и одновременно радует.
Замечательно наносится на кожу, распределяется по ее поверхности, не оставляет ощущения липкости и стянутости. Примерно через месяц после использования растяжки перестали виднеться, кожа выровнялась. Не стесняюсь носить шорты и бикини.
Благодарна тете за совет и рекомендую попробовать замечательный крем!
Крем отличается легкой текстурой, имеет жидкую консистенцию, но небольшой расход. Впитывается быстро, не оставляет жирных следов на одежде. Присутствует ярко выраженный, но не надоедливый аромат.
Некоторые отзываются о нем не самым лучшим образом, но в целом вполне достойное средство, позволяющее разрешить многие ваши проблемы.
Эффективность оценивается на среднем уровне, подойдет скорее в качестве профилактики, нежели в качестве лечения.
| Объем, в мл | 100 |
| Производитель | Россия |
| Компоненты | алоэ вера, жожоба, витамин Е |
Цена: около 200 рублей.
Приятно удивлена. В рамках соотношения цена-качества крем идеален. Не оставляет жирного блеска и неприятной пленки, быстро впитывается. Кожа после него мягкая и приятная на ощупь. Из недостатков – высокий расход средства. Нравится все, буду пользоваться дальше и ждать большего эффекта.
Крем наносится на поврежденные и деформированные части тела – живот и бедра, ягодицы и молочные железы. Верным решением с вашей стороны будет использование крема еще до того, как появились видимые дефекты, так как от уже сформировавшихся растяжек избавиться будет непросто.
| Составные ингредиенты | масло жожоба, миндаль, витамины С и Е |
| Страна-производитель | Россия |
| Объем упаковки, в мл | 150 |
Цена: от 299 до 429 рублей.
Крем радует все больше и больше, от применения к применению. Не имеет резкого неприятного запаха. Растяжки хоть медленно, но рассасываются.
На их месте кожа подтянутая и напитанная энергией. Рекомендую всем девушкам, которые находятся в поиске идеального крема против растяжек.
Кстати, его допустимо наносить во время беременности, в составе отсутствуют раздражители и синтетические добавки.
В составе средства исключительно натуральные компоненты, в частности миндальное масло и вытяжка арники. Аромат ярко выраженный, нравится далеко не всем, но пользовательницы отмечают отличный эффект, поэтому запах уходит на задний план. Высокая жирность не способствует быстрому впитыванию, вам потребуется некоторое время – около 20-30 минут. Излишки средства уберите салфеткой.
| Объем, в мл | 100 |
| Страна | Россия |
| Ингредиенты | миндальное масло, зародыши пшеницы, вытяжка арники |
Цена: от 89 до 129 рублей.
Средство привезла мама в качестве подарка с другой косметикой. Она в курсе моих проблем и растяжек, и хотела помочь. Поначалу скептически отнеслась к подобного рода маслу, не верила в действие.
Но потом решила попробовать. Результат приятно удивил, начиная от нанесения и заканчивая замечательным эффектом примерно через месяц.
Я вновь довольна фигурой и состоянием кожи, растяжки рассосались, глубокие и устаревшие стали светлее на несколько оттенков.
Специалисты рекомендуют использовать крем с 8 по 10 недели беременности, а также в случае высоких физических нагрузок. Консистенция настолько жидкая, что крем буквально вытекает из тюбика.
Расходуется в большом количестве, многие пользовательницы считают данный фактор отрицательным. Тем не менее, крем замечательно питает кожу, увлажняя ее, не оставляя липкого налета и пленки.
Достоинство – приятный и совершенно ненавязчивый аромат.
| Компоненты | витаминный комплекс, масло жожоба, экстракт ромашки, масло авокадо, лупеол, пептиды |
| Страна | Франция |
| Объем, в мл | 200 |
Цена: от 1300 до 1405 рублей.
Неплохой крем. Радует приятный аромат. В составе нет компонентов, вызывающих аллергическую реакцию, что важно, ведь я по природе аллергик. Рекомендую девушкам со свежими растяжками – стрии уходят намного быстрее, оставляя лишь светлую и чистую кожу.
Крем имеет приятную консистенцию, приходящуюся по душе многим пользовательницам. Она не плотная и не жидкая, легко наносится, распределяется по коже даже в малых количествах. Подходит простому и массажному нанесению.
Крем защищен мембраной от вскрытия, 150 мл хватает надолго. Экономичный расход, отсутствие отдушек, натуральный легкий аромат – далеко не все достоинства замечательного продукта.
Наносят с первых недель беременности – безопасность состава доказана гинекологами.
| Упаковка, в мл | 150 |
| Производство | Болгария |
| Ингредиенты | миндальное молочко, масло жожоба, витамины С и Е |
Цена: от 427 до 470 рублей.
Нареканий по действию крема не имею. Замечательно наносится, имеет приятный аромат. Стоимость также вполне демократичная, ради красоты могу себе позволить. Растяжки стали уходить примерно через 5 недель использования, но медленно. Меня и такой результат радует, ведь до этого совершенно ни один крем не мог мне помочь.
Крем один из немногих, прошедший все клинические испытания. Получил официальное подтверждение на гипоаллергенность состава. Представляет собой нежирную текстуру, быстро впитывающуюся и обеспечивающую увлажнение и глубокое питание кожи. Будущей маме нет смысла беспокоиться о безопасности малыша – состав натуральный, без отдушек и синтетических добавок.
| Страна | Англия |
| Компоненты, состав | оливковое масло, витаминный и минеральный состав |
| Объем, в мл | 200 |
Цена: от 940 до 1350 рублей.
Полезное приобретение стоит на моей полочке красоты. Использую 2 раза в неделю, растяжки у меня свежие и светлые.
К тому же подарила сестре – она на 7 месяце, и в качестве профилактики ей не помешает. Питает кожу, оставляет приятный аромат, нет липкости и жирного блеска. Крем не пачкает кожу, нравится мне составом.
Советую всем молодым красавицам, стремящимся к идеальной коже в любой части тела!
В таблице ниже мы еще раз перечислим все характеристики и черты представленных кремов. Сравнив их друг с другом, вам будет намного проще выбрать идеальное средство.
| Название крема | Страна | Объем, в мл | Ингредиенты |
| Sanosan Mama | Германия | 50 | глицерин, гибискус, масло жожоба |
| Mama Comfort Против растяжек | Россия | 100 | алоэ вера, жожоба, витамин Е |
| 9 месяцев Крем для профилактики и коррекции растяжек | Россия | 150 | масло жожоба, миндаль, витамины С и Е |
| Weleda Schwangerschafts-Pflegeöl | Россия | 100 | миндальное масло, зародыши пшеницы, вытяжка арники |
| Mustela Stretch Marks Prevention | Франция | 200 | витаминный комплекс, масло жожоба, экстракт ромашки, масло авокадо, лупеол, пептиды |
| Maternea Anti-Stretch Marks Body Cream | Болгария | 150 | миндальное молочко, масло жожоба, витамины С и Е |
| Avent Indulgent Body Cream | Англия | 200 | оливковое масло, витаминный и минеральный состав |
Профилактика стрий (растяжек) начинается в подростковом возрасте. Достаточно осуществлять правильный косметический уход за кожей и проблемными зонами, контролировать собственное питание. Врачи и опытные специалисты также предупреждают: легче предотвратить растяжки, чем лечить их, ведь процедуры, особенно профессиональные, стоят немалых денег и требуют немалого количества времени.
- Раз в неделю делайте маски, обертывания с водорослями. Процедуры позволят повысить тонус и эластичность кожи, сделают ее упругой и мягкой.
- Соблюдайте рацион, придерживайтесь правильного питания. Пейте не менее 2-х литров жидкости в день, чтобы предотвратить обезвоживание организма.
- Следите за весом, худейте постепенно, не более чем на 2% от общей массы тела в месяц. Если будете делать все медленно, то кожа будет адаптироваться и трансформироваться также постепенно, не потеряет тонус и не соберется в неприятные складки.
В выборе идеального крема от растяжек обратите внимание на несколько основных нюансов. Их много, и перед походом в магазин постарайтесь проанализировать каждый из них и определить, какое средство подойдет вам лучше всего. Среди критериев в особой степени обратите внимание на:
- Степень запущенности вашего тела. Растяжки могут быть свежими, а бывают и совсем устаревшими. Определить их давность вы можете по оттенку. Ярко розовые растяжки говорят о том, что вам не хватает коллагена, и растяжки совсем новые. Старые окрашены в фиолетовый и бурый оттенки.
- Назначение крема. Подумайте хорошенько над тем, с какой целью вы берете косметику. В магазинах выставляют разную продукцию – предназначенную глубокому восстановлению эпидермиса и для исключительно профилактических целей. Разница в цене ощутима.
- Состав. В креме присутствуют активные компоненты, направленные на борьбу с растяжками. Гиалуроновая кислота, протеины, кремний и витаминный комплекс. Видите их в составе – смело берите крем.
- Индивидуальные потребности и непереносимость. Перед покупкой дополнительно проконсультируйтесь с дерматологом, проведите тест на аллергию. Он делается точно так же, как и со всеми остальными косметическими продуктами.
Крем от растяжек Sanosan, отзывы о котором можно найти в продолжении статьи, является популярным средством, к которому прибегает почти каждая третья женщина во время беременности. Постоянные колебания гормонального фона в период вынашивания младенца приводят к тому, что женщины с ужасом отмечают неблагоприятные изменения состояния кожи.
Отзывы о креме от растяжек Sanosan помогут создать наиболее полную картину его воздействия: люди говорят, что натуральное средство немецкого происхождения, созданное специально для беременных, не приносит никакого вреда ни им, ни их детям.
Необходимо использовать данный крем на протяжении всего периода беременности и три месяца после родов. Это поможет избежать появления стрий и дряблости кожи, а также поддержать кожу в хорошем состоянии до и после беременности.
Также, согласно врачебным отзывам, крем от растяжек Sanosan эффективно поддерживает эластичные свойства кожи в период активного роста.
В такой волнительный период жизни – вынашивание ребенка — каждая мамочка заботится о своем питании и состоянии своей кожи.
Для этого необходимо не только подбирать правильный рацион питания, но и средства по уходу за кожей. Конечно же, все мамочки заботятся в первую очередь о здоровье своего малыша. Но ведь малышу еще нужна молодая и красивая мама, которая не комплексует по поводу своей внешности, всегда мила и добродушна.
Женская красота – сокровище каждой представительницы прекрасного пола, и, помимо желания сохранить в целости и сохранности свое чадо, в каждой женщине должна присутствовать королева, которая не позволит ей распуститься и утратить свой шарм и очарование.
Как утверждают многочисленные отзывы, крем от растяжек Sanosan является безопасной, гипоаллергенной косметикой. Использование данного средства поможет всем девушкам и женщинам чувствовать себя прекрасными. Особенно отмечают беременные крем от растяжек Sanosan mama. Отзывы же о средстве могут быть как положительными, так и отрицательными. Но первых все же больше.
Отзывы о данном средстве поступают в основном положительные. Во многом это определяет натуральность компонентов. Крем изготавливается исключительно из природных составляющих. В его состав входят следующие компоненты:
- хитозан;
- вытяжка из семян гибискуса;
- масло жожоба;
- оливковое масло;
- молочные и пшеничные протеины.
Не содержит крем парафиновых масел, красителей. Поэтому можно сказать, что он является безвредным для всех: для будущих мам, кормящих мам и их малышей. Далее разберем состав покомпонентно.
Масло жожоба является отличным увлажнителем. С ним кожа становится эластичнее и мягче. Главное преимущество данного масла заключается не только в его гипоаллергенности, но и универсальности – оно подходит всем типам кожи. Кроме того, масло используется даже при наличии кожных заболеваний.
Впервые он был получен из хитина в 1859 году. Хитозан оказывает противогрибковое, заживляющее, увлажняющее, антибактериальное действия. Благодаря гиалуроновой кислоте в своем составе он ускоряет регенеративные процессы в клетках и замедляет старение кожи. Отличается антицеллюлитным эффектом (в подтверждение тому можно видеть реальные отзывы о креме от растяжек Sanosan).
Экстракт гибискуса содержит в себе огромное количество полезных веществ, микроэлементов и минералов. Эту вытяжку еще называют гибискин. Благодаря ей средство повышает упругость и тонус кожи.
Это белок, который предупреждает воспаления и различного рода покраснения на коже. Он способствует обновлению эпидермиса и стимуляции роста новых, молодых. После него кожа становится бархатистой и гладкой – об этом свидетельствуют отзывы покупателей о креме от растяжек Sanosan.
Протеины пшеницы, которые входят в состав крема, омолаживают, питают, тонизируют кожу за счет активизации выработки коллагена. Они обеспечивают кислородное питание клеток, выравнивают и подтягивают кожный покров, защищают от излучения ультрафиолета и вредной окружающей среды.
Еще до нашей эры была доказана польза оливкового масла. С давних времен оно используется для ухода за волосами и кожей, употребляется с пищей для насыщения организма полезными витаминами и укрепления иммунитета. Нанесенное на кожу оливковое масло нормализует функции эпидермиса, наполняет его необходимыми микроэлементами и витаминами.
Фирма ООО Mann&Schroeder GmbH (Германия) разработала целую линейку средств, чтобы каждый мог выбрать наиболее подходящее для него средство. Линия средств Sanosan, помимо крема включает в себя масла и лосьоны-спреи.
Вся косметика содержит практически одинаковую концентрацию регенерирующих веществ.
Стоит отметить тот факт, что все средства данной линии средств прошли клинические испытания и являются безопасными.
Крем «Саносан» выпускается в мягком тюбике на 100 мл. Цена средства колеблется в районе 300-800 рублей в зависимости от региона. Лосьон-спрей продается в аптеках в удобном для нанесения флаконе (200 мл) с пульверизатором. Стоимость флакона с лосьоном несколько дороже – от 500 рублей. Масло же отпускается в небольшой бутылочке с объемом 100 мл.
Приобрести перечисленные товары можно в специализированных магазинах, аптеках, а также заказать в интернет-магазине.
Самое дешевое средство из серии, конечно же, крем. Его легко наносить, он быстро впитывается. Но хватает его ненадолго, в отличие от лосьона.
При использовании кремов от растяжек, как и при применении любых других профилактических и лекарственных средств, следует придерживаться рекомендаций. Данный крем имеет следующие: крем следует наносить дважды в день с помощью массирующих движений на места, более всего подверженные растяжкам (грудь, живот, бедра). Между нанесениями должен быть промежуток в 12 часов.
Применение средства необходимо начинать с ранних сроков.
Для лучшего эффекта можно дополнить крем остальными средствами из серии Sanosan.
«Саносан мама» – это линия средств, специально предназначенная для ухода за кожей во время вынашивания ребенка и периода лактации.
Крем Sanosan не только результативно обеспечивает профилактику стрий, но и помогает избавляться от них.
Положительные свойства:
- снижается вероятность появления стрий;
- уменьшается ареал существующих растяжек;
- сохраняется красота и здоровье кожи;
- увлажняет, насыщает витаминами и микроэлементами;
- является безопасным;
- возможно применение на раннем сроке беременности;
- имеет относительно небольшую стоимость.
Но, как говорится, не бывает средств без отрицательных свойств. К ним относятся:
- долгое впитывание крема за счет густой консистенции;
- может вызвать схватки после втирания на последних сроках беременности.
Последний факт опять же предупреждает нас, что на поздних сроках консультация у врача – жизненно важное дело. Если вместо массажа использовать другой способ, возможно, беременной удастся избежать таких неожиданностей.
Согласно женским отзывам, крем от растяжек для беременных Sanosan действительно обеспечивает профилактику растяжек.
Это значит, что без использования крема беременность обернулась бы целой плеядой стрий на теле у молодых мамочек.
Точь-в-точь в соответствии с отзывам врачей о креме от растяжек Sanosan, ведь дерматологи советуют применение крема в большей степени для профилактики и возможного (подчеркивается!) удаления небольших и неглубоких стрий.
Как пишут молодые мамочки, крем порадовал своей ценой и приятным запахом. Они довольны составом крема и отмечают, что им удалось избежать такой напасти как растяжки. Однако не всех устраивает длительное впитывание продукта, после применения кожа будто липкая, говорят они.
Те, у кого уже начали появляться растяжки, но вовремя забили тревогу, смогли с помощью крема обрести былую гладкость кожи. Не устраивает людей инструкция к средству — хотелось бы более подробного описания.
Также крем весьма популярен среди худеющих.
Известная проблема – при наборе или скидывании веса кожа постепенно теряет свою эластичность, и в итоге мы получаем стрии, избавиться от которых довольно сложно, как показывает практика. Достаточно лишь раз распуститься – и лишний вес с растяжками тут как тут, пишут люди.
Устрашенные данной перспективой они готовы на все – даже на покупку не совсем дешевого крема от растяжек. Вопреки положительным отзывам, не стоит ожидать чудодейственного исцеления от стрий – редко уже сформированная растяжка позволит «изгнать» себя с насиженного места.
Чтобы крем действительно справился со своей задачей, крайне важно учесть главные нюансы выбора. Их довольно много, поэтому перед походом в магазин постарайтесь проанализировать все из них и определить, какое средство подойдет больше всего. Среди основным критериев выделяют:
- Степень запущенности. Растяжки могут быть как свежими, так и старыми. Чтобы определить их давность, достаточно взглянуть на их оттенок. Ярко-розовый цвет имеют стрии свидетельствуют о нехватке коллагена, поверхностном повреждении и сроке до 2 месяцев. Светло-розовый или голубой тон говорит о начале процесса заживления, таким растяжкам 2-3 месяца. Самые старые окрашиваются в фиолетовый или бурый цвет.
- Назначение. Подумайте, для чего именно вы приобретаете подобную косметику. В магазинах есть продукция, направленная на глубокое восстановление эпидермиса и та, что оказывает исключительно профилактическое воздействие. При этом цена между ними весьма существенна.
- Состав. В любом креме из ТОП-10 присутствуют активные компоненты для борьбы с растяжками. Это гиалуроновая кислота, различные витамины, протеины и кремний. Если нужен дополнительный уход, обратите внимание на косметику с маслами.
- Индивидуальная непереносимость. Если вы сомневаетесь, подойдет ли крем именно вам, лучше проконсультироваться с доктором или провести тест на аллергию. Он делается так же, как и со всеми другими косметическими продуктами.
Немаловажным вопросам является выбор бренда, ведь во многом от этого будет зависит стоимость косметического средства. Старайтесь избегать чересчур дешевой продукции. Скорее всего, в ней будет много вредной химии и минимум полезных компонентов. Есть довольно бюджетные кремы и гели от отечественных компаний. Обратите внимание на те, что имеют хорошие отзывы.
Составляя список лучшей продукции от растяжек были приняты во внимание такие факторы как стоимость, эффективность крема, его безопасность и наличие дополнительного ухода за кожей. Именно эти параметры являются основополагающими.
Лосьоны и масла расходуются экономичнее, поэтому их хватает на более долгий срок. Но они всегда оставляют жирноватую пленку на коже, нередко плохо впитываются и пачкают одежду. Если этот эффект недопустим, стоит выбрать крем с легкой текстурой. Также тюбик удобнее брать с собой в поездку, не боясь протеканий.
При ограниченном бюджете стоит обратить внимание на отечественную продукцию, например, косметику от Mama Comfort или Weleda. В первую очередь важна эффективность? Обратите внимание на продукцию Bayer, AVENT или Mustela. Описание продукции есть в нашем рейтинге.
Обычно средства от растяжек наносятся два раза в день (утром и вечером), поэтому расход достаточно большой. Если средство нужно для профилактики, достаточно флакона от 100 мл, для регулярного применения и борьбы с застарелыми стриями следует покупать косметику объемом от 200 мл и более.
Все зависит от состава средства. Витамины способствуют регенерации, как правило в крем добавляют витамины С, Е, А. Сделать кожу более эластичной поможет гиалуроновая кислота. Глицерин повысит эластичность. Протеины позволят удержать влагу.
Во время вынашивания плода или вскармливания следует подбирать кремы, в составе которых отсутствуют отдушки, парабены, силиконы и витамин А.
Растяжки, срок которых не превышает 6-9 месяцев, могут быть убраны с помощью специального средства. Если же стрии застарели слишком сильно, следует использовать более радикальные методы, например, лазерную шлифовку.
Назвать самое лучшее средство от растяжек крайне сложно, поскольку каждый преследует собственные цели. Тем не менее, есть рейтинг лучших производителей 2020 года. Именно эти компании стали лидерами по количеству продаж и положительных отзывов о своей продукции.
- 1 Mustela — французская торговая марка, которая специализируется на выпуске косметики для будущих и состоявшихся мам, а также для их малышей. Учитывая, что компания сотрудничает с представителями здравоохранения, все средства максимально безопасны.
- 2 StriaSan — это линия продуктов от немецкой компании, направленная на борьбу с растяжками. Кремы от стрий, входящие в нее, способствуют выработке коллагена и укрепляют кожу. Они полностью безопасны и подходят для кормящих мам.
- 3 Weleda — отечественный бренд, предлагающий женщинам органическую косметику, в том числе и недорогие средства от растяжек. Примечательно, что производитель всегда делает ставку на антропософскую медицину, проводит исследования, относящиеся к биопроцессам.
- 4 Vichy — люксовая французская косметика от известного бренда пользуется популярностью среди женщин по всему миру. Она отличается эффективностью, всегда имеет привлекательный дизайн и приятный аромат. Некоторые средства могут содержать отдушки.
- 5 Maternea — болгарская торговая марка, имеющая линию для беременных женщин. Средства не вызывают аллергии, характеризуются экологической чистотой и прошли множество тестов. Они доказали свою эффективность и доступны каждому покупателю.
Также спросом пользуются средства от стрий от компаний ELANCYL, Bayer, Palmers, Mama Comfort и Clarins.
- Наиболее доступная цена
- Страна: Россия
- Цена: 200 Р
- (2019): 4.5
Крем имеет легкую текстуру и жидкую консистенцию, поэтому очень быстро впитывается в кожу.
Присутствует выраженный аромат, что некоторым не по душе. Средство оставляет тонкую пленку на коже, расходуется в минимальном количестве. Объем флакона составляет 100 мл.
Эффективность средняя, больше подходит для профилактики, нежели для лечения.
Достоинства
- Доступная стоимость
- Легко распределяется
- Экономичный расход
Недостатки
- Очень жидкая консистенция
- Лучшее соотношение цены и качества
- Страна: США
- Цена: 650 Р
- (2019): 4.8
На фото вы видите популярный крем с потрясающим запахом какао. Он имеет плотную текстуру, отлично питает кожу. В тубе находится 125 мл средства.
Его можно использовать во время беременности, поскольку он предотвращает появление стрий. Если таковые появились, он тоже поможет, осветлит и сделает растяжки менее заметными. Первый результат можно увидеть уже через 2 недели использования.
В составе есть масла, поэтому он дополнительно увлажняет эпидермис.
Достоинства
- Эффективность
- Хорошо питает
- Быстро впитывается
Недостатки
- Сладкий аромат нравится не всем
- Очень быстро впитывается
- Страна: Германия
- Цена: 375 Р
- (2019): 4.8
Довольно бюджетное средство иностранного производства по сравнению с другими марками.
Он не только предотвращает появление стрий, но и уменьшает их количество на теле. В составе есть глицерин, цинк, гибискус, масло жожоба, лимонная кислота и пчелиный воск. Крем имеет очень густую консистенцию, но не оставляет липкой пленки. Снимает зуд и хорошо питает кожу.
Если наносить его на все проблемные зоны, тюбика хватит на 2-3 недели.
Достоинства
- Хорошо впитывается
- Уменьшает растяжки
- Подходит для зимы
Недостатки
- Не содержит отдушек и парфюмов
- Страна: Болгария
- Цена: 470 Р
- (2019): 4.9
Консистенция этого крема многим нравится, поскольку она не слишком плотная и не жидкая.
Средство легко наносится и распределяется по коже. Отлично подходит для массажа. Крем защищен мембраной от вскрытия, в тюбике находится 150 мл средства. Он экономично расходуется, не имеет отдушек, поэтому пахнет натурально.
Его можно наносить, начиная с первых недель беременности.
Достоинства
- Натуральный аромат
- Оптимальная консистенция
- Борется со стриями
Недостатки
- Старые растяжки убирает плохо
- Самая легкая текстура
- Страна: Германия
- Цена: 600 Р
- (2019): 4.9
Эмульсия против растяжек обладает приятной консистенцией, моментально распределяется по телу и впитывается, не оставляя неприятной липкости.
Это средство часто попадает в обзоры экспертов и молодых мам, которые испытали его в действии. Пользователи отмечают очень удобный флакон с дозатором, в нем 150 мл средства.
В эмульсии есть провитамин B5, глицерин, оливковое масло, декспантенол, а также экстракт центеллы.
Достоинства
- Есть дозатор
- Легкая консистенция
- Адекватный ценник
Недостатки
- Отлично подходит для профилактики стрий
- Страна: Франция
- Цена: 1070 Р
- (2019): 4.7
Крем продается в тюбике 150 и 500 мл.
Он считается одним из лучших средств для профилактики растяжек, также может убирать не очень старые стрии, не до конца, но он их делает почти незаметными.
Крем хорошо питает и увлажняет, поскольку в составе присутствуют пантенол, масло миндаля, сорбиновая кислота. Большого флакона хватает примерно на 2-3 месяца, поэтому лучше приобретать его.
Достоинства
- Хороший запах
- Не пачкает одежду
- Экономичность
Недостатки
- Лучшее масло от растяжек
- Страна: Россия
- Цена: 80 Р
- (2019): 4.7
В составе есть миндальное масло, зародыши пшеницы, вытяжка арники и другие эфирные масла, то есть он полностью натуральный.
Аромат выражен ярко, что нравится далеко не всем женщинам, особенно при беременности. Высокая жирность не способствует быстрому впитыванию, масло следует оставлять на 20-30 мин на коже, излишки убирать салфеткой.
Объем флакона составляет 100 мл.
Достоинства
- Натуральный состав
- Удобный флакон
- Универсальность
Недостатки
- Безвредный состав
- Страна: Германия
- Цена: 2000 Р
- (2019): 4.8
Немецкий крем продается во флаконах по 150 мл. Производитель предлагает два вида крема: один дородовой, другой — послеродовой.
Желательно использовать их в комплексе, что предупредит появление растяжек. Средство быстро впитывается, хорошо питает кожу. Консистенция не плотная, поэтому расходуется не очень экономно. В составе отсутствуют парабены, силиконы и отдушки.
Достоинства
- Высокая эффективность
- Не наносит вреда
- Не имеет запаха
- Лучший для груди
- Страна: Нидерланды
- Цена: 500 Р
- (2019): 4.
9
Основными компонентами средства являются ланолин, кокосовое масло, экстракт алоэ вера, поэтому оно хорошо увлажняет соски и убирает даже глубокие трещины, способствуя быстрому заживлению.
Его можно наносить даже перед кормлением и не смывать. Крем не вызывает аллергии, имеет нежную консистенцию, легко и очень быстро впитывается, не оставляя следов. Пользователи отмечают экономичный расход.
Достоинства
- Водоросли в составе
- Безопасность
- Разглаживает неглубокие стрии
- Средство проверенное временем
- Страна: Франция
- Цена: 1305 Р
- (2019): 5.9
Средство рекомендуется использовать с 8-10 недели беременности или при сильных физических нагрузках.
Консистенция крема жидкая, он вытекает из тюбика, расходуется в большом количестве. Он хорошо питает и увлажняет кожу, имеет положительные отзывы относительно эффективности.
В составе есть масло ши, пептиды авокадо, лупеол, повышающие эластичность кожи и снижающие ее “реактивность” Приятный ненавязчивый запах также является плюсом.
Достоинства Недостатки Рекомендуем посмотреть видео